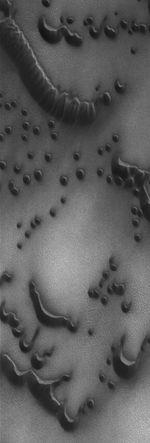

Description
13 January 2004
This Mars Global Surveyor (MGS) Mars Orbiter Camera (MOC) image shows dark sand dunes in the north polar region of Mars. The dominant winds responsible for these dunes blew from the lower left (southwest). They are located near 76.6°N, 257.2°W. The picture covers an area 3 km (1.9 mi) across; sunlight illuminates the scene from the upper right.